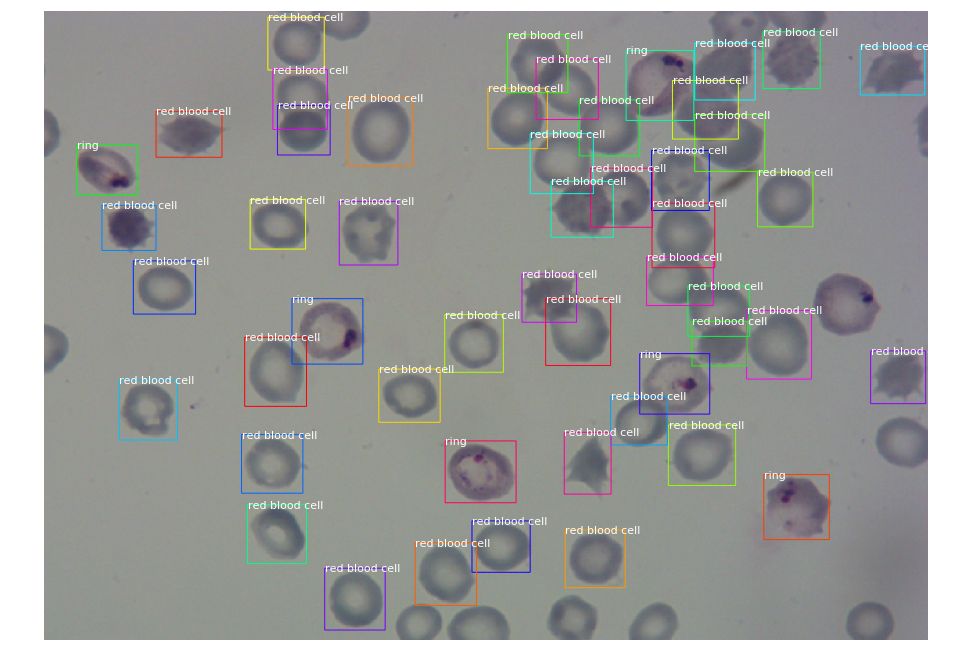
Computer Vision Techniques: Implementing Mask-R CNN on ...

43 red blood cell with labels
Red blood cells - Blood - GCSE Biology (Single Science) Revision - BBC ... Red blood cells transport oxygen for aerobic respiration. They must be able to absorb oxygen in the lungs, pass through narrow blood vessels, and release oxygen to respiring cells ... PDF RED BLOOD CELLS LABELING TECHNIQUES Clinical Uses @ Various drugs have been found to significantlylower the red blood cell labeling efficiency: 1. Hydralazine 2. Prazosin 3. Methyldopa 4. Propranolol 5. Digoxin 6. Quinidine 7. Doxorubicin 8. Cyclosporin (Sufficient concentration of stannous ions in the blood may minimize the poor labeling problem. 9.
2009 Labels on a Bag of Packed Red Cells - The Complete Version What is hidden behind the big labels? What is SAGM? SAGM is a combination of constituents as additive solution to give the red cell optimum viability. It actually stands for - Sodium Chloride: provides isotonicity - Adenine: maintains ATP for red cell viability - Glucose: supports red cell metabolism - Mannitol: helps reduce red cell lysis

Red blood cell with labels
red blood cell diagram labelled | Today red blood cell diagram labelled newest information, everything today. . red blood cell diagram labelled. Label Animal Cell Organelles - Labelled diagram - Wordwall. Seret dan lepaskan pin ke tempat yang betul pada imej.. mitochondria, nucleus, golgi apparatus, cell membrane, vacuole, centriole. ... Red Blood Cell Diagram - TessagroMercado An animal cell is made of three main parts a nucleus cell membrane and. These red blood cells stacks impair blood flow through capillaries that can only fit a single blood cell through at a time. Cell death by cytotoxic T cells in immune mechanisms such as in graft-versus-host disease and rejection reactions. Chromium-labeled red blood cells - Radiopaedia Chromium-labeled red blood cells is an intravascular MRI contrast agent.. The use of 51 Cr-labeled RBCs in nuclear medicine suggested the use of paramagnetic Cr(III)-labeled RBCs as an intravascular contrast agent for MRI. In dogs, significant enhancement of the liver and spleen is noted with minimal enhancement of the kidneys.
Red blood cell with labels. Labeled Diagram Red Blood Cell Vector Free | AI, SVG and EPS Free Labeled Diagram Red Blood Cell vector download in AI, SVG, EPS and CDR. Browse our Labeled Diagram Red Blood Cell images, graphics, and designs from +79.322 free vectors graphics. Radiolabeled Red Blood Cells: Method and Mechanisms duration. In-111 labeled red blood cells have been proposed for detection of gastrointestinal bleeding and red blood cell sequestration and survival studies. In-111 oxine is a suitable product for labeling red blood cells as an off-label use. Lipid-soluble complexes of Ga-67 and Ga-68 have also been reported as alternatives to more common Radionuclide-labeled red blood cells: current status and ... Radiolabeling of red cells and their clinical and research application in nuclear medicine constitute an area of continued interest and steady growth during the past two decades. Significant advances have been made so that at the present time, radiolabels with sufficient in vitro and in vivo stability are available for diverse applications. Red blood cell life span in the ovine fetus - PubMed we conclude the following: 1) red cell life span in the fetal circulation is short compared with the adult; 2) red cells in younger fetuses have shorter life spans than in near-term fetuses; 3) the curvilinear disappearance of labeled red cells in the fetus appears to be due primarily to an expanding blood volume with fetal growth; and 4) red …
Component labelling | Lifeblood The ISBT 128 labelling standard is internationally recognised and improves blood component traceability for the safety of patients and donors. Blood component labels contain clinically important information specific to each individual unit. These labels can also have modifier texts, such as red cell phenotype or CMV antibody status. Red blood cell diagram royalty-free images - Shutterstock 2,146 red blood cell diagram stock photos, vectors, and illustrations are available royalty-free. See red blood cell diagram stock video clips Image type Orientation Color People Artists More Sort by Popular Biology Science Geography and Landscapes Healthcare and Medical red blood cell blood vessel blood oxygen hemoglobins medicine Next of 22 Labeling of Red Blood Cell Units with Historical Antigen ... Labeling of Red Blood Cell Units with Historical Antigen Typing Results Guidance for Industry Additional copies of this guidance are available from the Office of Communication, Outreach and... PDF ISBT 128 Blood and Blood Component Label Examples - ICCBBA Red Blood Cells - Irradiated 12. Red Blood Cells - Leukocytes Reduced and Irradiated ISBT 128 Blood and Blood Component Label Examples US Label Examples of Product Types Needed for FDA Review Last updated: 10 Jan 2020 Page 7 of 15 13. Apheresis Red Blood Cells 14. Apheresis Red Blood Cells - Leukocytes Reduced
SB128-20-33 | Red Blood Cells Product Labels for ... - Shamrock Labels 2" x 2"1"RL500Glossy ColdstickPermanentWhiteBlackE0162V00 / RED BLOOD CELLS / IRRADIATED / LEUKOCYTES REDUCED / From 450 mL CPD Whole Blood / Store at 1 to Blood group labels - Transfusion Guidelines The blood group label is part of a complete overstick label and must be attached to the blood collection pack and/or satellite pack in the appropriate place immediately adjacent to the donation number. This is to allow a continuous straight-line read of the combined labels. Label dimensions are defined below: 44 mm ±1 mm wide × 99 mm ±1 mm deep 48,073 Red blood cells Images, Stock Photos & Vectors - Shutterstock 48,073 red blood cells stock photos, vectors, and illustrations are available royalty-free. See red blood cells stock video clips Image type Orientation Color People Artists More Sort by Popular Biology Healthcare and Medical Anatomy Geography and Landscapes Icons and Graphics red blood cell medicine blood cell vein Next of 481 Labeling of Red Blood Cell Units with Historical Antigen ... Center for Biologics Evaluation and Research We, FDA, are issuing this guidance document to provide you, establishments that collect blood and blood components for transfusion, with recommendations...
Red Blood Cell Diagram Labeled stock illustrations Browse 19 red blood cell diagram labeled stock illustrations and vector graphics available royalty-free, or start a new search to explore more great stock images and vector art. Newest results. Human gas exchange system vector illustration.
DailyMed - ULTRATAG RBC- technetium tc 99m-labeled red blood ... Dec 19, 2019 · Ultratag™ RBC (kit for the preparation of technetium Tc 99m-labeled red blood cells) is a sterile, nonpyrogenic, diagnostic kit for the in vitro preparation of technetium Tc 99m-labeled red blood cells. Prior to lyophilization, the pH is adjusted to 7.1 to 7.2 with sodium hydroxide. The contents of the vial are lyophilized and stored under argon.
Blood Cell Images | Kaggle This dataset contains 12,500 augmented images of blood cells (JPEG) with accompanying cell type labels (CSV). There are approximately 3,000 images for each of 4 different cell types grouped into 4 different folders (according to cell type). The cell types are Eosinophil, Lymphocyte, Monocyte, and Neutrophil.
Blood Cell Labelling - Esco Pharma 99mTc Labelled Red Blood Cells (RBCs) Using the isotope of technetium- 9 9m ( 99m Tc) to label red blood cells in nuclear cardiology is well established. This isotope is able to efficiently distribute itself inside the body's intravascular pool and subsequently, able to leave it at a slow rate.
Technetium-99m-labeled red blood cells in the evaluation of hemangiomas ... Scintigraphic evaluations with technetium-99m-labeled red blood cells offers an accurate method of identification of these lesions, and allows differentiation from other common primary or secondary hepatic masses in infancy or childhood. This scintigraphic method may also be used to follow these patients after medical, radiation, or ...
Labeling - AABB Each label must have information that contains, at a minimum, a unique facility identifier, a lot number relating to the donor, a product code, and the ABO and Rh of the donor. The requirements are applicable to all blood and blood components, including autologous units collected within a hospital and to all aliquots, syringes and pools.
Labeled red blood cell hi-res stock photography and images - Alamy Labeled red blood cell Stock Photos and Images. RM 2BE0HBY - SEM of a gold (Au) labeled red blood cell. Red blood cells (RBCs), also called erythrocytes, are the most common type of blood cell and the vertebrate's principal means of delivering oxygen (O2) to the body tissues- via blood flow through the circulatory system.
Blood Histology Slides with Description and Labeled Diagram The cells of the blood are three major types - erythrocytes (Red Blood Cells), leukocytes (White Blood Cells), and Platelets (Thrombocytes). ... All the blood cell histology labeled diagrams might be helpful for you to identify them so quickly. The neutrophil contains heterochromatic segmented nuclei with three to five lobes. Again, the ...
RBC Blood Test: Normal Ranges and Diagnostic Uses - Verywell Health A count of your red blood cells to determine if they are within a normal range. The red blood cell (RBC) count is a test that measures the number of oxygen-carrying blood cells in your blood. An abnormal RBC test result is often the first sign of an illness. At other times, the test can point the doctor in the direction of a diagnosis if there ...
Red Blood Cells Labels - Shamrock Labels Red Blood Cells Labels. Home > Blood Bank > ISBT Printed Product Labels > Red Blood Cells Labels. Anesthesia (2847) Labeling Tape (951) Date, Time & Initial Labeling Tape (316) Expiration Date, Time & Initial Labeling Tape (318) Imprinted Labeling Tape (316) Pre-Cut Labels (1901) Pack Form (951)

Axis Scientific Anatomy Model of Human Red Blood Cells, Enlarged Model with Cellular Detail of Plasma, Platelets, Granulocytes, and Monocytes, ...
Red blood cell - Wikipedia Vertebrate red blood cells consist mainly of hemoglobin, a complex metalloprotein containing heme groups whose iron atoms temporarily bind to oxygen molecules (O 2) in the lungs or gills and release them throughout the body. Oxygen can easily diffuse through the red blood cell's cell membrane.
Red blood cells | Radiology Reference Article | Radiopaedia.org During this process in humans, the red blood cell nuclei are expelled. Labeled erythrocytes are often used in nuclear medicine, e.g. Tc-99m labeled erythrocytes can be used to assess GI bleeding. Normal red blood cells live about 120 days before destruction, however certain diseases will alter the survival time of these cells.
Chromium-labeled red blood cells - Radiopaedia Chromium-labeled red blood cells is an intravascular MRI contrast agent.. The use of 51 Cr-labeled RBCs in nuclear medicine suggested the use of paramagnetic Cr(III)-labeled RBCs as an intravascular contrast agent for MRI. In dogs, significant enhancement of the liver and spleen is noted with minimal enhancement of the kidneys.
Red Blood Cell Diagram - TessagroMercado An animal cell is made of three main parts a nucleus cell membrane and. These red blood cells stacks impair blood flow through capillaries that can only fit a single blood cell through at a time. Cell death by cytotoxic T cells in immune mechanisms such as in graft-versus-host disease and rejection reactions.
red blood cell diagram labelled | Today red blood cell diagram labelled newest information, everything today. . red blood cell diagram labelled. Label Animal Cell Organelles - Labelled diagram - Wordwall. Seret dan lepaskan pin ke tempat yang betul pada imej.. mitochondria, nucleus, golgi apparatus, cell membrane, vacuole, centriole. ...

Post a Comment for "43 red blood cell with labels"